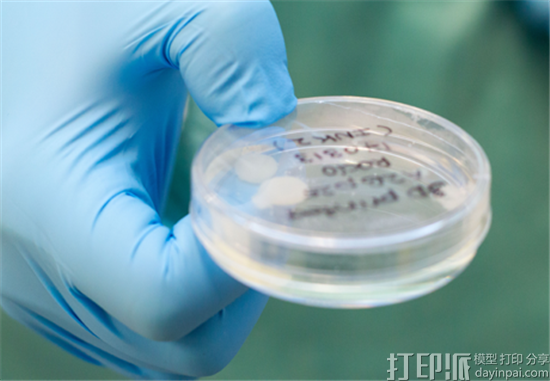
瑞典研究人员通过3D打印人体膝盖干细胞成功创建软骨组织

dy19932017-05-03 15:10:38
生物3D打印的挑战之一是获得构成生物“墨水”的干细胞,以便在3D打印过程中生存下去,更不用说保持它们能够生长成全组织结构。此前,我们听到很多关于生物3D打印成功案例,但是我们并没有听到很多失败的案例。 3D打印人体组织是不容易的事情,所以每次需要提前进行研究。
一个多月前,一批瑞典研究人员,其中包括来自Sahlgrenska学院的研究人员,他们不仅将3D打印的人类软骨细胞植入小鼠,而且在植入后能够生存下去,并能够成长。细胞在3D打印后立即植入,并在小鼠中成功形成自己的血管网络,这向最终3D打印人体器官植入迈出了重要一步。
现在,Sahlgrenska学院发布了进一步的消息。研究人员与Chalmers理工大学合作的研究团队已经通过3D打印人体膝盖干细胞成功地创建了软骨组织。从接受膝关节手术的患者中取出细胞,经实验室操作后,它们还原成多功能干细胞,可发展成多种不同类型的细胞。

然后将细胞与纳米纤维素的溶液混合并将其打印成预定结构。打印完成之后,用生长激素处理,使其分化形成软骨组织。据悉,组织是三年努力工作的结果。
“在本质上,干细胞分化成软骨是一个简单的过程,但是在试管中要复杂得多。”Sahlgrenska学院细胞生物学副教授Stina Simonsson表示:“我们是第一个获得成功的团队,而且我们没有进行任何动物试验。我们研究了各种方法,结合不同的增长因素。每个单独的干细胞被纳入纳米纤维素,这使得它能够在打印成3D结构的过程中存活。我们还从包含干细胞用于相互通信的其他细胞中收获培养基。按照外行人士的说法,我们的理论是,我们设法欺骗细胞,认为它们并不孤单。”

通过“欺骗”细胞,研究小组能够让它们在繁殖之前进行区分。团队意识到,大量的干细胞是组织形成所必需的。当外科医生检查生物3D打印软骨时,那些外科医生发现3D打印组织和天然存在的人类软骨之间没有差异。
在现实应用方面,这一突破意味着在不久的将来,可能会从患者自身提取干细胞中进行3D打印新的软骨。生物打印组织可用于修复受损软骨或治疗退行性疾病,如骨关节炎。尽管如此,但还需要继续进行研究。

Simonsson说:“我们使用的纤维素的结构可能不是最适合人体使用的。在我们开始研究将生物3D打印软骨纳入患者手术治疗的可能性之前,我们需要找到另一种可以被细胞分解和吸收的材料,以便保留只有内源性软骨,最重要的在临床环境中使用的东西是安全的。”
据悉,该篇研究论文Simonsson是主要作者,另外的作者包括Duong Nguyen、DanielA.Hagg、Alma Forsman、Josefine Ekholm、Puwapong Nimkingratama、Camilla Brantsing、Theodoros Kalogeropoulos、Samantha Zaunz、Sebastian Concaro、Mats Brittberg、Anders Lindahl、Paul Gatenholm和Annika Enejder。
评论 (0)